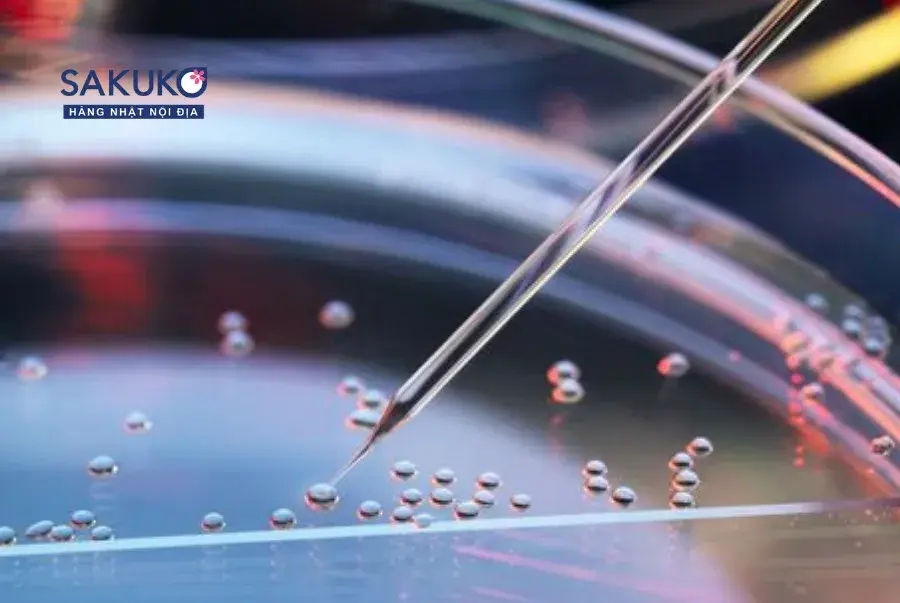
z4791127797582_774c62a94eeab8d60b4e53371a200933_be37d13771054ee792960c0de10c6eb2 Tế bào gốc và sự thật

Tế bào gốc và sự thật “chạy đua” tiêu dùng của giới thượng lưu
Tế bào gốc và sự thật “chạy đua” tiêu dùng của giới thượng lưu
“Tế bào gốc” là từ khóa quen thuộc trong giới thượng lưu và đang gây sốt trong cộng đồng làm đẹp thời gian gần đây. Vậy tế bào gốc thực sự là gì và tại sao nó lại thu hút sự quan tâm của những người giàu có nhất thế giới? Hãy cùng khám phá ngay sau đây!
Tế bào gốc là gì?
Tế bào gốc là những tế bào có khả năng tự tái tạo và biến đổi thành các loại tế bào khác trong cơ thể. Điều này có nghĩa là chúng có khả năng sửa chữa tổn thương, thay thế tế bào cũ, và thậm chí là tái tạo các cơ quan và mô tế bào hoàn toàn mới. Khả năng này khiến cho tế bào gốc trở thành một trong những phát triển quan trọng nhất trong lĩnh vực y học và làm đẹp.
Tại sao tế bào gốc lại gây sốt trong cộng đồng giới thượng lưu?
Tế bào gốc đã nhanh chóng trở thành hiện tượng trong cộng đồng giới thượng lưu. Khả năng sửa chữa tổn thương và trẻ hóa sinh học tế bào mang lại hy vọng cho những người giàu có muốn duy trì sức khỏe và vẻ đẹp của mình trong thời gian dài. Không chỉ là một công cụ để chống lão hóa, tế bào gốc còn có tiềm năng trong việc điều trị các bệnh lý nghiêm trọng và cải thiện chất lượng cuộc sống.
Câu lạc bộ R360 – Nơi tụ hội những triệu phú triệu đô tại Mỹ chính là một ví dụ điển hình của việc ứng dụng tế bào gốc trong trẻ hóa tuổi sinh học. Họ đã tìm được cách duy trì tuổi thanh xuân, cải thiện sức khỏe và không ngần ngại chi ra hàng triệu đô la để “trì hoãn cái chết” nhờ tế bào gốc.
Fioretti – Doanh nhân bất động sản đồng thời là thành viên Câu lạc bộ R360 đã chia sẻ: “Trọng tâm là chăm sóc, phòng ngừa để giữ gìn sức khỏe chứ không phải giải quyết các vấn đề khi nó đã xảy ra”. Đó mới chính là tinh thần thượng lưu và tầm nhìn xa của những người giàu có.
Tế bào gốc và những công dụng tuyệt vời
Ở mảng y học, tế bào gốc đã làm bùng nổ hy vọng cho hàng triệu bệnh nhân trên khắp thế giới. Chúng đã được áp dụng để điều trị các bệnh nguy hiểm như bệnh ung thư, bệnh tim mạch, bệnh khớp và thậm chí cả những bệnh về thần kinh.
Tại Việt Nam, công nghệ tế bào gốc đã được ứng dụng thành công trong việc điều trị bỏng và ung thư máu, mang lại hy vọng và cơ hội mới cho những người bệnh. Ngoài ra, tế bào gốc còn đóng vai trò quan trọng trong lĩnh vực nghiên cứu và phát triển các loại thuốc mới, hứa hẹn sẽ thay đổi nền y học nước nhà.
Không chỉ trong lĩnh vực y tế, tế bào gốc còn là một “công cụ thần kỳ” trong lĩnh vực làm đẹp. Chúng có khả năng bảo trì và tái tạo cơ bản, giúp cải thiện làn da và nâng cao vẻ đẹp tự nhiên một cách đáng kể. Điều này đã tạo nên một làn sóng mới trong ngành làm đẹp, giúp cho việc chăm sóc da không còn đơn thuần là thẩm mỹ mà còn là một sứ mệnh y học toàn diện.
82X ứng dụng tế bào gốc trong sản phẩm 82X Stem Cell
82X tự hào là thương hiệu đầu tiên có chứa tế bào gốc trong sản phẩm Nước uống collagen và tăng cường sức khỏe nữ. Bộ đôi 82X Stem Cell Collagen & Placenta chính là “kết tinh” cho nghiên cứu chuyên sâu của các nhà khoa học tại công ty Mashiro, Nhật Bản.
Sản phẩm đã ứng dụng thành công tế bào gốc hoa hồng Damask để sửa chữa DNA, trẻ hóa sinh học tế bào dựa trên 4 cơ chế quan trọng:
- Bảo vệ: Bảo vệ tế bào khỏe mạnh khỏi gốc tự do và các yếu tố gây hại
- Hồi sinh: Phục hồi tổn thương tế bào, tạo điều kiện sao chép những DNA khỏe mạnh
- Tái tạo: Tạo môi trường thuận lợi để tế bào gốc nội sinh gia tăng tự nhiên
- Nuôi dưỡng: Duy trì lượng tế bào gốc dự trữ để thay thế cho tế bào gốc kém chức năng
Sản phẩm còn “ghi điểm” sự kết hợp giữa 82 thực vật lên men, men Peptide và chiết xuất nấm trắng. “Công thức nhân 3” này có tác dụng tăng cường miễn dịch, tăng cường trao đổi chất và thải độc cơ thể, đồng thời giúp phái nữ thon gọn vóc dáng, kiểm soát cân nặng hiệu quả.
Tạm kết
Tế bào gốc đã trở thành “chìa khóa” cho sức khỏe, khiến giới thượng lưu “chạy đua” để tìm kiếm giải pháp kéo dài tuổi thọ. Thành phần quý giá này còn được ứng dụng trong ngành làm đẹp, giúp trẻ hóa tuổi sinh học cho cơ thể, đặc biệt là làn da.
Với 82X Stem Cell Collagen & Placenta, bạn sẽ có thêm trợ thủ đắc lực giúp bạn phòng chống bệnh tật, làm chậm quá trình lão hóa từ sâu bên trong, ổn định thể trạng và đẹp mãi cùng thời gian.
Konni39hanoi tự hào phân phối các sản phẩm chính hãng 82X Stem Cell Collagen & Placenta, đồng hành cùng bạn trong hành trình trẻ hóa sắc đẹp và nâng cao chất lượng cuộc sống. Qua ngay các cơ sở Konni39hanoi trên toàn quốc để rinh về những sản phẩm chính hãng với giá ưu đãi nhất!
Deal hấp dẫn tặng bạn tháng 10 này:
- Giảm ngay 15% cho mọi đơn hàng mua 82X Stem cell
- Tặng thêm hộp mặt nạ nâng cơ, trẻ hóa cao cấp 300.000đ
- Cơ hội quay số trúng thưởng Iphone Promax cùng hàng nghìn phần qua hấp dẫn tổng trị giá tới 1 TỶ ĐỒNG
Đặt hàng ngay:
- Stem Cell Collagen: https://konni39hanoi.com/cham-soc-sac-dep/tpcn-lam-dep/collagen/api-thuc-uong-82x-stem-cell-collagen-500g
- Stem Cell Placenta: https://konni39hanoi.com/san-pham/api-thuc-uong-82x-stem-cell-placenta-500g

Chăm sóc cơ thể
Chăm sóc da mặt
Chăm sóc răng miệng
Chăm sóc tóc
Dụng cụ làm đẹp
Chống nắng
Dưỡng môi & mi
Dưỡng trắng
Giấy thấm dầu
Mặt nạ
Nước hoa hồng
Serum & kem dưỡng
Sữa rửa mặt
Tẩy da chết
Tẩy trang
Bàn chải
Chỉ nha khoa
Kem đánh răng
Nước súc miệng
Xịt họng
Cạo râu
Dầu gội – Dầu xả
Nhuộm tóc
Tẩy lông
Trang điểm mắt
Trang điểm mặt
Collagen
Enzyme
Hỗ trợ mọc tóc
Tăng & giảm cân
Seedcoms
Trẻ hóa làn da
Trị nám
Tăng cường sức khỏe
Bổ dạ dày
Bổ não
Bổ phổi & gan
Bổ xương khớp
Tăng cường sinh lý
Hỗ trợ điều trị
Đồ dùng nấu bếp
Đồ điện đun nấu
Nồi chảo Oceno
Đồ dùng cá nhân
Băng vệ sinh
Bao cao su
Đồ dùng khác
Nhà bếp
Dao & Kéo
Hóa phẩm nhà bếp
Hộp đựng thức ăn
Nước rửa chén bát
Phòng ăn
Bình nước, bình giữ nhiệt
Dung dịch tạo hương
Đồ dùng phòng tắm
Giặt xả
Diệt & chống côn trùng
Ngoài trời & sân vườn
Đồ sửa chữa
Chăm sóc cơ thể bé
Gội đầu – Sữa tắm cho bé
Phấn, kem dưỡng da cho bé
Khăn giấy ướt
Chăm sóc sức khỏe cho bé
Hạ sốt
Tai mũi họng
Tăng chiều cao
Vitamin & khoáng chất
Chăm sóc răng miệng cho bé
Nước súc miệng
Đồ dùng cho bé
Bình sữa – Bình tập uống
Dụng cụ tập ăn
Đồ chơi
Gặm nướu, ti giả
Tã – Bỉm
Đồ dùng cho mẹ
Thực phẩm bổ sung cho mẹ
Thực phẩm cho bé
Bánh ăn dặm
Cháo & bột ăn dặm
Bánh kẹo cho bé
Gia vị nấu nướng cho bé
Hạt nêm
Mì chính, đường, muối
Nước dùng
Nước tương
Kẹo cao su
Thạch
Bánh
Kẹo
Socola
Đồ uống
Nước giải khát
Trà – Coffee
Sữa dinh dưỡng
Thực phẩm ăn liền
Đồ hộp
Ngũ cốc
Đồ lót
Khẩu trang & Túi